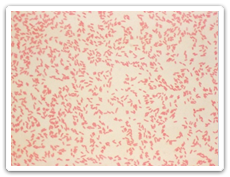

Yersiniosis (Yersinia enterocolitica or Y. pseudotuberculosis)
Yersiniosis is an intestinal illness caused by the bacteria Yersinia. When a person becomes ill from the infection it is called yersiniosis.
Yersiniosis is an intestinal illness caused by the bacteria Yersinia. When a person becomes ill from the infection it is called yersiniosis.
Image Content Provider: CDC
Symptoms
Symptoms generally appear approximately three to seven days after the person has become infected and usually include fever, abdominal pain, and bloody diarrhea. Some infections can mimic appendicitis.
Causes
Yersiniosis is spread by the fecal-oral route by eating or drinking contaminated food, especially raw or undercooked pork, unpasteurized (raw) milk, and untreated water, or by direct or indirect contact with infected people or animals. Fecal material can get into a person’s mouth by contact with the feces of an infected person or animal that is not followed up by proper hand washing. Rarely the organism is transmitted through contaminated blood during a transfusion. The infection is more common in the winter.
Treatment
Most people will recover on their own without treatment.
Prevention
Illness is preventable by protecting food and water from fecal contamination as well as by practicing good hand hygiene, especially before and after using the bathroom, changing diapers, or touching animals. Hand hygiene when preparing food and before eating is important, especially after handling pork. Do not drink raw milk or raw milk products. Avoid drinking untreated surface water (e.g. from lakes, rivers, springs or ponds). Avoid eating raw pork.
Manitoba Health Resources
For the Public
For Health Care Providers
Other Resources
- BC Centre for Disease Control - Yersinia Infection
- Centers for Disease Control and Prevention - Yersinia
Information for Travelers
Communicable Disease
Control (CDC) Health Links – Info Santé |



